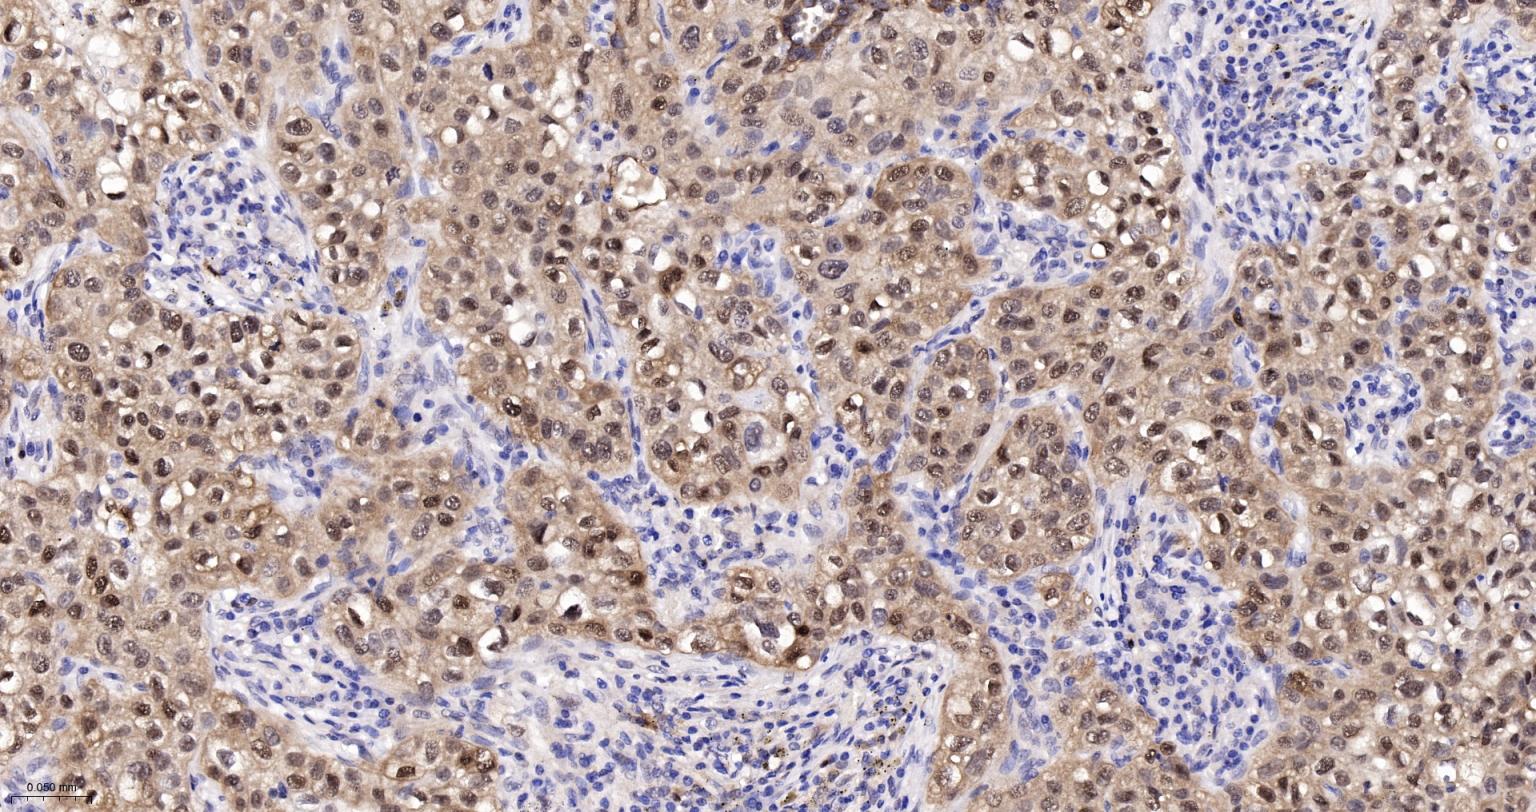
热休克蛋白-70重组兔单抗
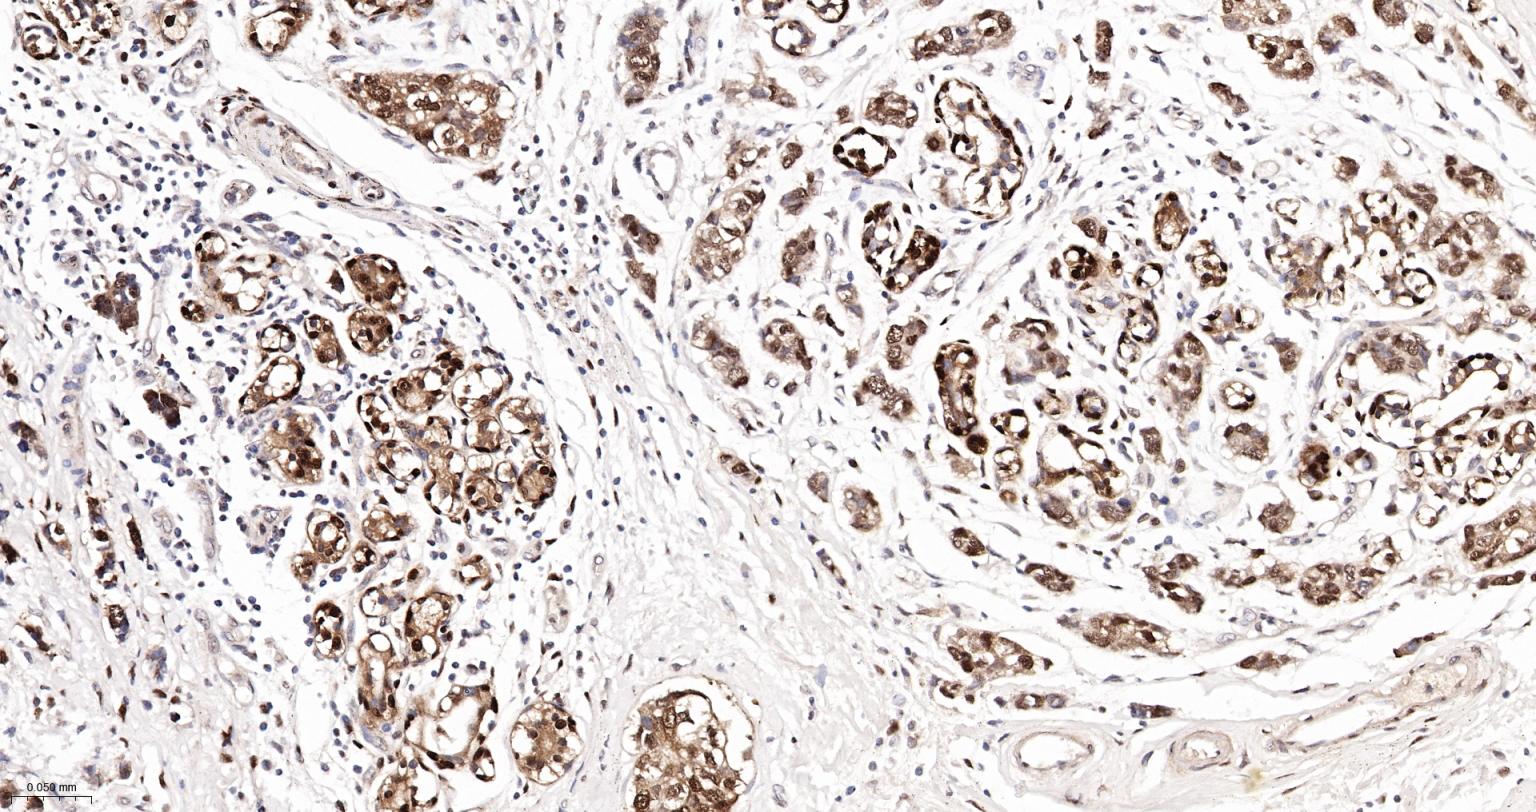
热休克蛋白-70重组兔单抗
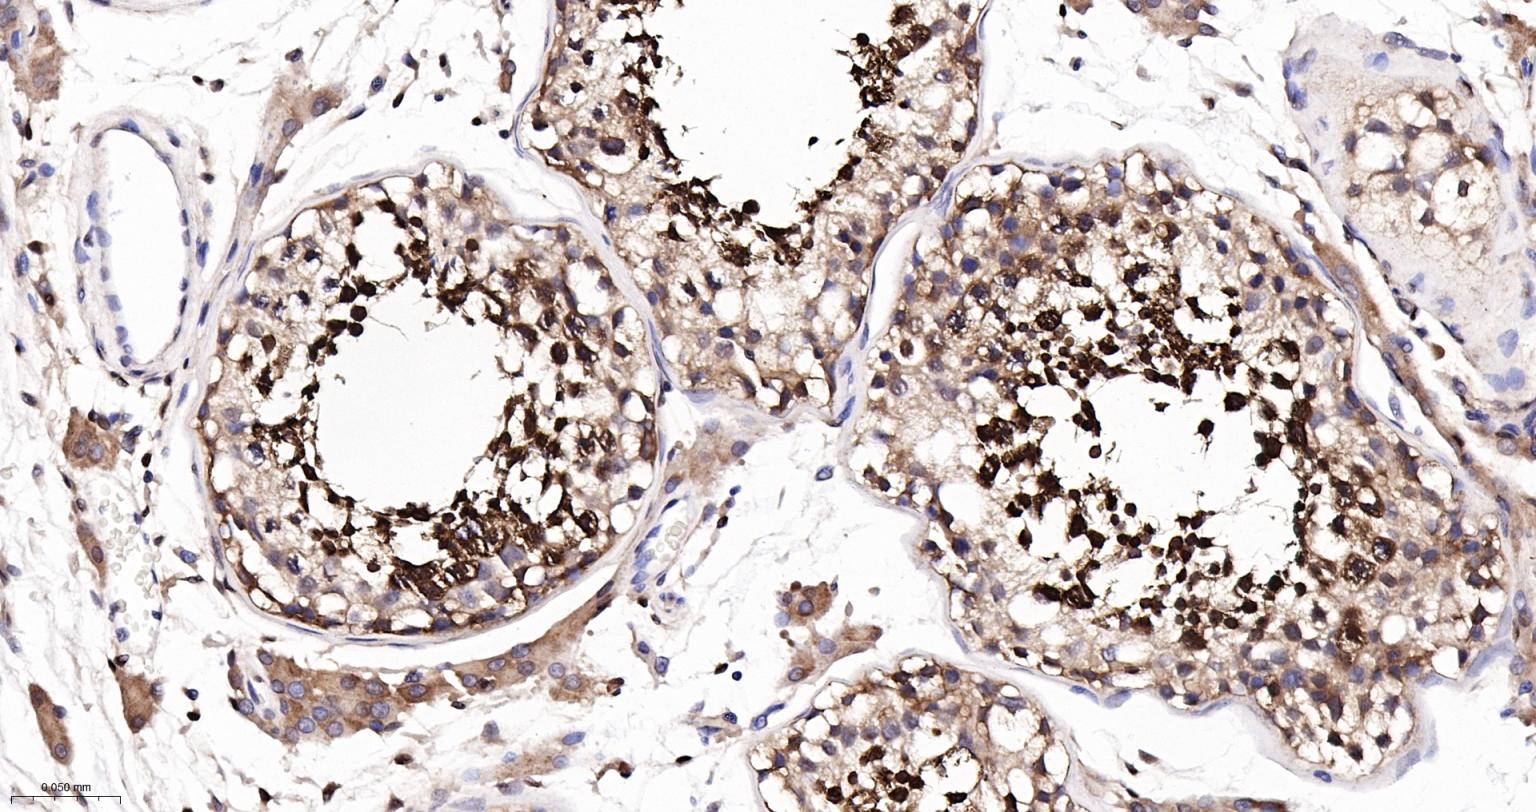
热休克蛋白-70重组兔单抗

HSP70 Recombinant Rabbit mAb (一抗) - WB,IHC-P,IHC-F,IF,Flow-Cyt,ICC/IF | Bioss
Rrmab?兔单抗

货号:bsm-52241R
产品详情
相关标记
相关产品
相关文献
常见问题
概述
产品编号
bsm-52241R
产品类型
重组兔单抗、mIHC精品抗体
英文名称
HSP70 Recombinant Rabbit mAb
中文名称
热休克蛋白-70重组兔单抗
英文别名
HSP70-1; HSPA1; HEL-S-103; HSP70; HSP70-1A; HSP70-2; HSP70.1; HSP70.2; HSP70I; HSP72; Hsp70-3; Hsp70.3; hsp68; hsp70A1; Hspa1a; Hspa2; HS71A_BOVIN; Heat shock 70 kDa protein 1 (HSP70.1); HS71A_HUMAN; Heat shock 70 kDa protein 1 (HSP70-1 | HSP70.1); Heat shock protein family A member 1A; HSX70; HS71B_HUMAN; HSPA1B; Heat shock 70 kDa protein 2 (HSP70-2 | HSP70.2); Heat shock protein family A member 1B; HS71B_MOUSE; Hcp70.1; HS71A_MOUSE; Heat shock 70 kDa protein 3 (HSP70.3); HSP71_RAT;
抗体来源
Rabbit
免疫原
A synthesized peptide derived from human Hsp70: 400-641
亚型
IgG
性状
Liquid
纯化方法
affinity purified by Protein A
克隆类型
Recombinant
克隆号
2G2
理论分子量
70 kDa
检测分子量
68 kDa
浓度
1mg/ml
储存液
0.01M TBS (pH7.4) with 1% BSA, 0.02% Proclin300 and 50% Glycerol.
研究领域
SWISS
Gene ID
保存条件
Shipped at 4℃. Store at -20℃ for one year. Avoid repeated freeze/thaw cycles.
注意事项
This product as supplied is intended for research use only, not for use in human, therapeutic or diagnostic applications.
数据库链接
产品介绍
HSP-70是细胞受应激原刺激后诱导产生的一组应激蛋白,与肿瘤发生、增殖及分化有关。环境和病生理性应激原均可导致肌体合成一组应急蛋白既热休克蛋白。许多热休克蛋白,包括HSP70家族成员,均参与蛋白的变性-复性、折叠-解折叠、运输-易位、活化-非活化和分泌等过程。 HSP70与类固醇受体、肌动蛋白、P53等蛋白密切相关。HSP70还参与热应激原、细胞毒药物和其他损伤所引起的应急反应,对机体起一定的保护作用。
背景资料
This intronless gene encodes a 70kDa heat shock protein which is a member of the heat shock protein 70 family. In conjuction with other heat shock proteins, this protein stabilizes existing proteins against aggregation and mediates the folding of newly translated proteins in the cytosol and in organelles. It is also involved in the ubiquitin-proteasome pathway through interaction with the AU-rich element RNA-binding protein 1. The gene is located in the major histocompatibility complex class III region, in a cluster with two closely related genes which encode similar proteins. [provided by RefSeq, Jul 2008].

产品应用
| 应用 | 已检合格种属 | 预测种属 | 推荐稀释比例 |
|---|---|---|---|
| WB | Human, Mouse, Rat | 1:1000-2000 | |
| IHC-P | Human, Mouse, Rat | 1:200-500 | |
| IHC-F | Human, Mouse, Rat | 1:200-500 | |
| IF | Human, Mouse, Rat | 1:200-500 | |
| Flow-Cyt | Human | Mouse, Rat | 1:50-100 |
| ICC/IF | Human | Mouse, Rat | 1:50-200 |
交叉反应
交叉反应: Human, Mouse, Rat
相关产品
暂无相关产品
靶标
基因名
HSPA1A
蛋白名
Heat shock 70 kDa protein 1A
亚基
Component of the CatSper complex. Identified in a mRNP granule complex, at least composed of ACTB, ACTN4, DHX9, ERG, HNRNPA1, HNRNPA2B1, HNRNPAB, HNRNPD, HNRNPL, HNRNPR, HNRNPU, HSPA1, HSPA8, IGF2BP1, ILF2, ILF3, NCBP1, NCL, PABPC1, PABPC4, PABPN1, RPLP0, RPS3, RPS3A, RPS4X, RPS8, RPS9, SYNCRIP, TROVE2, YBX1 and untranslated mRNAs. Interacts with TSC2. Interacts with IRAK1BP1. Interacts with TERT; the interaction occurs in the absence of the RNA component, TERC, and dissociates once the TERT complex has formed. Interacts with DNAJC7. Interacts with CHCHD3.
亚细胞定位
Cytoplasm. Note=Localized in cytoplasmic mRNP granules containing untranslated mRNAs.
组织特异性
HSPA1B is testis-specific.
相似性
Belongs to the heat shock protein 70 family.
功能
In cooperation with other chaperones, Hsp70s stabilize preexistent proteins against aggregation and mediate the folding of newly translated polypeptides in the cytosol as well as within organelles. These chaperones participate in all these processes through their ability to recognize nonnative conformations of other proteins. They bind extended peptide segments with a net hydrophobic character exposed by polypeptides during translation and membrane translocation, or following stress-induced damage. In case of rotavirus A infection, serves as a post-attachment receptor for the virus to facilitate entry into the cell.
同靶标产品
相关文献
提示: 发表研究结果有使用 bsm-52241R 时请让我们知道,以便我们可以引用参考文章。作为回馈,资料提供者将获得我们送上的小礼品。